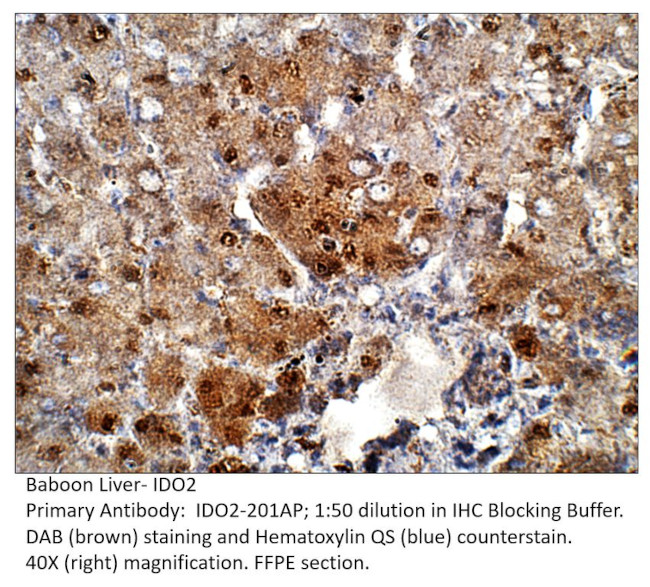
Indoleamine 2 3-dioxygenase 2 Antibody in Immunohistochemistry (IHC)

Search
Fabgennix
Indoleamine 2 3-dioxygenase 2 Polyclonal Antibody
{{$productOrderCtrl.translations['antibody.pdp.commerceCard.promotion.promotions']}}
{{$productOrderCtrl.translations['antibody.pdp.commerceCard.promotion.viewpromo']}}
{{$productOrderCtrl.translations['antibody.pdp.commerceCard.promotion.promocode']}}: {{promo.promoCode}} {{promo.promoTitle}} {{promo.promoDescription}}. {{$productOrderCtrl.translations['antibody.pdp.commerceCard.promotion.learnmore']}}
Product Details
IDO2-201AP
Species Reactivity
Host/Isotype
Class
Type
Immunogen
Conjugate
Form
Concentration
Purification
Storage buffer
Contains
Storage conditions
Shipping conditions
Target Information
Along with the enzymes encoded by the INDO and TDO2 genes, the enzyme encoded by the INDOL1 gene metabolizes tryptophan in the kynurenine pathway.
For Research Use Only. Not for use in diagnostic procedures. Not for resale without express authorization.
References (0)
Bioinformatics
Protein Aliases: 3-dioxygenase 2; 3-dioxygenase-like protein 1; EC 1.13.11.; IDO-2; INDOL 1; indoleamine 2; Indoleamine 2,3 dioxygenase 2; Indoleamine 2,3 dioxygenase like 1 protein; Indoleamine 2,3-dioxygenase 2; indoleamine 2,3-dioxygenase-like 1 protein; Indoleamine 2,3-dioxygenase-like protein 1; Indoleamine pyrrole 2,3 dioxygenase like 1; Indoleamine-pyrrole 2; indoleamine-pyrrole 2,3 dioxygenase-like 1; indoleamine-pyrrole 2,3-dioxygenase; Indoleamine-pyrrole 2,3-dioxygenase-like protein 1; unnamed protein product
Gene Aliases: IDO2; INDOL1
UniProt ID: (Human) Q6ZQW0
Entrez Gene ID: (Human) 169355

Performance Guarantee
If an Invitrogen™ antibody doesn't perform as described on our website or datasheet,we'll replace the product at no cost to you, or provide you with a credit for a future purchase.*
Learn more
We're here to help
Get expert recommendations for common problems or connect directly with an on staff expert for technical assistance related to applications, equipment and general product use.
Contact tech support